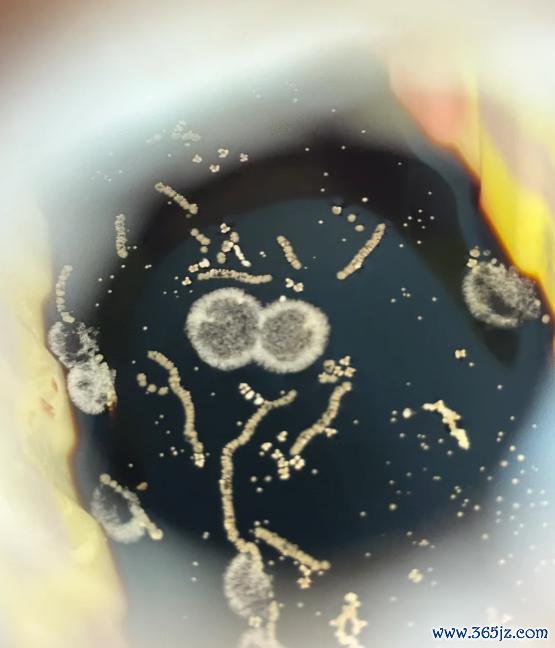

开云体育(中国)官方网站
开云体育(中国)官方网站
先问大家一个问题——
泛泛炒完菜,你是风气于把酱油往灶台上一放,还是放进雪柜?
盲猜一下,可能不少东谈主会选第一个选项,毕竟丁香医师的共事们也都是这么干的,作念完饭后,把酱油唾手一放,常温储存。
但这么的后果即是……我们径直看图吧� �
图片起首:� � 截图
长霉……

长霉……

长五彩斑斓的霉……何况,还可能生蛆� �

图片起首:� � 截图
炒菜时一不提防,吨吨吨倒进去,也算是加多卵白质了(bushi。
看到这里,你一定会握狂:为什么好好的酱油会形成这么?

因为大家健忘了一件事——
把 酱 油 放 冰 箱 !
酱油开封后最好放雪柜
低盐酱油必须放雪柜
服气不少东谈主有三不雅被刷新的嗅觉,毕竟从小挂念里,酱油都是放常温的。(还有东谈主不信邪,跑到厨房一看:如何的确要放雪柜?!)

图片起首:我方拍的
酱油高盐低水分的环境确乎有一定的抑菌防腐效用,但并不皆备,有些微生物在这种齁咸的环境下也能活。
有些霉菌对水活度(不错粗浅贯通为微生物或者诓骗的水分)的要求相对更低,更耐咸。
酱油的水活度一般在 0.80 独揽,大多量霉菌的最好孕育区间,在水活度 0.93~0.97 之间,在酱油里活不下去。但一些嗜干性霉菌,独一稍稍有点水就能活,要将水活度降至 0.60 以下才能有用阻碍其孕育。
霉菌除外,还有一些能耐受高盐条款的细菌和酵母,也能在这种高盐条款下养殖,尤其是芽胞杆菌这一类抗逆性较强的细菌,是导致酱油变质的常客。
一项推敲对变质酱油中的微生物进行测序分析,发现变质「凶犯」即是这一类细菌。

图片起首:文件 [ 1 ]
若是你家为了健康,买的是低盐 / 薄盐酱油,那防腐才能更低,开封后必须放雪柜保存。

低盐酱油的盐浓度频繁会减少 20% 以上,有的致使减少 50%,这就使得酱油中的水活度升高。

跟着食用盐异常添加量的加多,水活度呈线性裁减,反之盐越少,水活度就会线性加多。
图片起首:文件 [ 2 ]
再加上,酱油本人富含氨基酸、糖等养分物资,使得低盐酱油成为微生物孕育养殖的「优质温床」,发霉变质的风险蹭蹭往高潮。
一项发表在《食物化学》期刊上的推敲指出,跟着盐含量的裁减,细菌总额和败北菌加多,功能性微生物总额减少。 [ 3 ]

A 图,最低盐酱油细菌总额最多,最高盐酱油细菌总额最少;D 图,最低盐酵母菌数最少,最高盐酵母菌数最多。
图片起首:文件 [ 3 ]
频繁来说,低盐酱油明白过添加防腐剂来裁减变质风险。
但咫尺都追求「零添加」居品,有些低盐酱油干脆连防腐剂这第二层保护壳也不要了,尽量少添加,致使「零添加」,代价即是发霉变质的风险大大加多。

酱油中盐分的裁减,还会转折导致另一个后果:生蛆。
低盐酱油容易生蛆,倒不是盐少就我方生出来了(谣言),而是有的东谈主作念完饭后,健忘盖上瓶盖,此时虫蝇碰巧飞过(蝇虫对发酵食物气息进退失踞),就趁便产下了卵。
只不外在高盐环境中,卵可能孵化不出来,但在低盐环境中,卵轻轻易松就孵化了。
由此可见,酱油最适宜的保存时势即是:用完实时放雪柜,盖好瓶盖,不要敞口放。
说到这里,有东谈主一定念念问:那其他调料呢?厨房里的油盐酱醋到底该如何保存?
这 3 种保存时势
杜渐防萌整个盐油米面
谜底早就写在了包装上,举例低盐酱油,瓶身上就明确标注「开启后请冷藏」。
是以,使用前一定要看好包装上的储存条款。
事实上,绝大多量液态或半固态的调料都更提出在开封后冷藏,尤其是含油、含糖、含卵白质较高的调料,举例虾酱、鱼露、蛋黄酱、沙拉酱、花生酱、番茄酱等酱料。
这些酱料都有较高微生物浑浊风险,大部分此类调料也都在包装上注明了开封后冷藏保存。若是无法详情,提出一律密封、冷藏措置。
丁香医师和大师针对市面上多样调味品、油、米面干货等给大家分好了类,望望哪些需要放雪柜储存、哪些需要避光储存、哪些需要密封 + 干燥储存吧� �



好!假如今天的科普对你有用的话,求点赞、求点❤️、求转发,最贫困的是,转发给你身边爱作念饭的一又友家东谈主们吧!
天然知谈你们一定会吐槽:啥都要放雪柜!那得多大的雪柜才能都放得下!

本文合营大师

本文审核大师

参考文件
[ 1 ] 蒋雪薇 , 周尚庭 , 叶菁 , 等 . 制品变质酱油中微生物的诀别浮滑及变质原因分析 [ J ] . 食物与机械 , 2016, 32 ( 2 ) :5.
[ 2 ] 蒋木培 . 减盐酱油分娩推敲证实 [ J ] . 农居品加工(上半月), 2022 ( 008 ) :000.
[ 3 ] Hu, Guangyao et al. " Moromi mash dysbiosis trigged by salt reduction is relevant to quality and aroma changes of soy sauce. " Food chemistry vol. 406 ( 2023 ) : 135064. doi:10.1016/j.foodchem.2022.135064
[ 4 ] 李丹凤 . 影响酱油水分活度的身分推敲 [ J ] . 食物工业 , 2025, 46 ( 1 ) :85-87.
[ 5 ] 陈小聪 . 浅析固体饮料的水分活度与霉菌孕育的甘休 [ J ] . 企业科技与发展 ,2008 ( 18 ) :126-127.
[ 6 ] Riedl C A L, Oster S, Busto M, et al. Natural variability in Drosophila larval and pupal NaCl tolerance [ J ] . Journal of insect physiology, 2016, 88: 15-23.
[ 7 ] 香港破钞者委员会 . 調味品發霉?變味?不行不知的儲存要领 . https://www.consumer.org.hk/tc/article/526-condiment-storage/526_condiment_storage#:~:text=Image: jam
谋划制作
谋划:JJJ | 监制:Feidi
插图:见图注 | 封面图起首:我方拍的
最近微信改版了,有读者说找不到我们的著述
大家记起把丁香医师设为星标� � 哦~
 开云体育(中国)官方网站
开云体育(中国)官方网站
